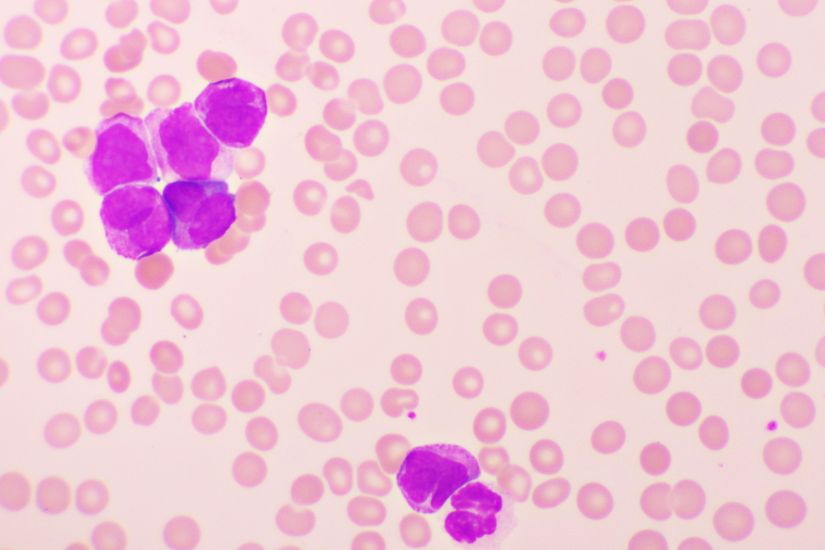

Deadline: 16-Feb-24
The Leukemia Research Foundation provides grants for new investigator research projects that will have an impact on leukemia.
Funding Information
- The maximum funding request is $150k over a two year period.
- The Leukemia Research Foundation does not provide funds for capital equipment (i.e., equipment purchases above $7,500). Any request for an exception to this policy must detail the specific need of the capital equipment for the proposed research project.
- Salary support for the principal investigator is not provided.
- Using funds for research travel is permitted but should not exceed $3K. The funds are intended only to enhance the study.
- All other support for the project must be detailed, including all sources for the requested and related projects. Any funding overlap must be clearly indicated.
- Indirect cost recovery or institutional overhead costs are not provided.
Eligibility Criteria
- Applicants must be independent investigators affiliated with a non-profit academic institution at the time funding commences and for the duration of the award.
- New investigators are considered to be within seven years of their first independent faculty-level position when the grant would be awarded. Years as a resident physician, fellow physician, or post-doctoral fellow are considered to be training years and are not included in the seven-year guideline.
- A researcher must be in an independent faculty-level position at the time the application is submitted. An independent position is a scientist who has dedicated laboratory space, directly hires and supervises laboratory personnel, and makes all decisions concerning research activities and use of the grant funds.
- Adjustments for career interruptions can be made. These could include but are not limited to family leave, military service, major illness, or injury. It is the responsibility of the applicant to point out and document such interruptions.
- Applicants are not required to be US citizens. Research projects from outside the US are eligible.
- Applicants with a KO8, R00, or R99 grant are eligible. The total grant amount will not be applied toward the $175K per year threshold on total direct costs.
- DOE, DOD, NSF, R21, or other grants with less than $175K per year in total direct costs are permitted.
- Only one LOI may be submitted from the same applicant (Principal Investigator).
Ineligible
- Applicants with any active single grant (or multiple grants added together) that total $175K or greater in total direct costs per year are not eligible (as noted above, KO8, R00, R99 grant awards are excluded from this total threshold).
- Fellows are not eligible to apply.
- Applicants with NIH RO1 funding, VA Merit Award, or equivalent.
- Renewal applications will not be accepted and investigators who have received a Leukemia Research Foundation new investigator award in the past are not eligible to apply.
- Co-PI’s are not permitted.
For more information, visit Leukemia Research Foundation.